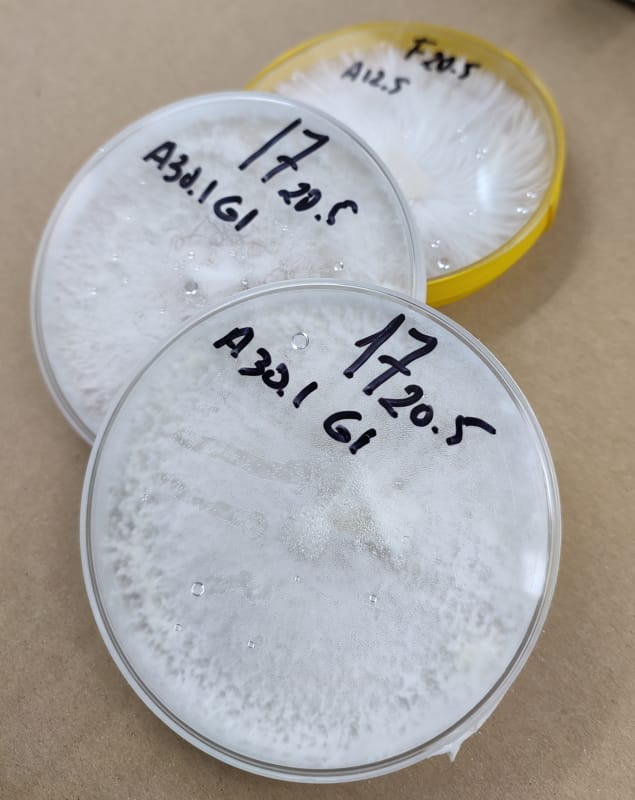

Micelio en placas petri
€ 25,41
En stock
Micelio en placas Petri. Varias cepas. G1/G2. Culturas madres.
Join Waitlist
We will inform you when the product arrives in stock. Please leave your valid email address below.
Descripción
Micelio desarrollado en placas Petri con medio nutritivo en base agar agar bacteriológico. Micelio de primera o segunda generación. Colonizada con diferentes cepas. Placas Petri de 90 mm a 100 mm. Idóneo para transferir a culturas liquidas, grano estéril u otra placa Petri. Renovado cada seis meses , lo que garantiza la frescura del micelio.